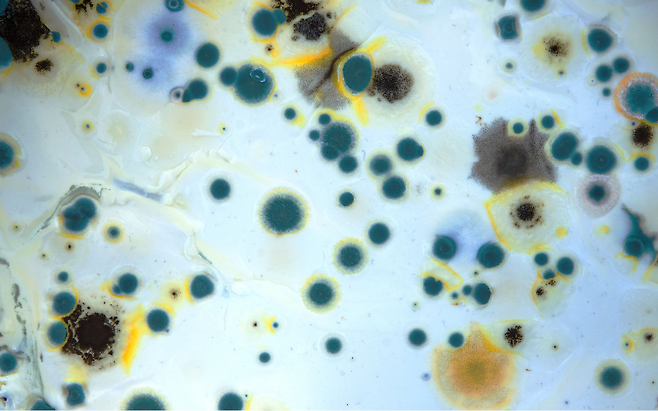

빨랫감은 자주 돌리면서도 두툼한 커튼은 ‘다음에’로 미루기 일쑤입니다. 하지만 먼지 덮인 커튼을 한 번만 털어도 보이지 않는 곰팡이 포자가 실내에 구름처럼 흩어집니다.
이 포자 속 독소는 호흡기 염증을 넘어 뇌세포까지 공격해 알츠하이머 위험을 끌어올리는 치명적 방아쇠로 작용합니다. 귀찮음을 방치하는 순간, 암덩어리 같은 곰팡이가 당신의 기억을 잠식할 수 있습니다.
커튼 먼지에 숨어 있는 곰팡이 포자

커튼은 직물 섬유와 주름 사이에 미세먼지·피부각질·수분이 쌓이면서 곰팡이가 번식하기 좋은 온실로 변합니다.
실제 조사에서 침대 매트리스·바닥 먼지와 함께 커튼 표면에서 검출된 곰팡이 알레르겐이 천식·비염 위험을 크게 높인다는 결과가 보고됐습니다.
곰팡이 독소가 뇌를 파괴하는 경로

곰팡이가 분비하는 마이코톡신은 호흡기를 통해 혈류로 들어가 혈-뇌 장벽을 교묘히 뚫고 침투합니다.
동물·임상 연구에서는 이러한 독소가 뇌 신경세포에 산화 스트레스를 유발해 알츠하이머와 같은 신경퇴행성 질환의 발병 위험을 높이는 것으로 확인됐습니다.
높은 습도·VOC와 합세한 ‘뇌 독소 칵테일’

장마철 실내 습도가 60%를 넘으면 커튼 조직이 항상 축축해져 곰팡이 증식 속도가 폭발적으로 빨라집니다.
동시에 커튼에 흡착된 휘발성유기화합물(VOC)이 포자와 뒤섞여 공기 중을 떠돌며, 이 복합 자극이 뇌혈관을 수축·이완시켜 편두통과 인지 저하 위험을 배가합니다.
커튼 세탁·건조만이 유일한 안전벨트
커튼은 최소 석 달에 한 번 60℃ 이상 온수로 세탁하고, 살균 기능이 있는 세제를 사용해 포자와 독소를 동시에 제거해야 합니다. 세탁 후에는 완전히 건조해 습기를 없애고, 장마철에는 제습기나 선풍기를 켜서 실내 습도를 45~50%로 유지하십시오.
천연 소재 커튼은 먼지 흡착력이 높으므로 주 1회 이상 진공청소기 브러시로 표면을 빨아들이면 재오염을 크게 줄일 수 있습니다.
커튼 먼지는 단순한 미관 문제가 아니라 수명 단축을 재촉하는 뇌 독소 저장소입니다. 정기 세탁과 철저한 건조만으로도 곰팡이 포자와 마이코톡신을 대폭 줄여 알츠하이머 위험을 낮출 수 있습니다.
오늘 창가 커튼을 걷어 보십시오. 작은 청소 습관이 기억과 건강을 지키는 가장 확실한 보험입니다.
Copyright © 뇌생각